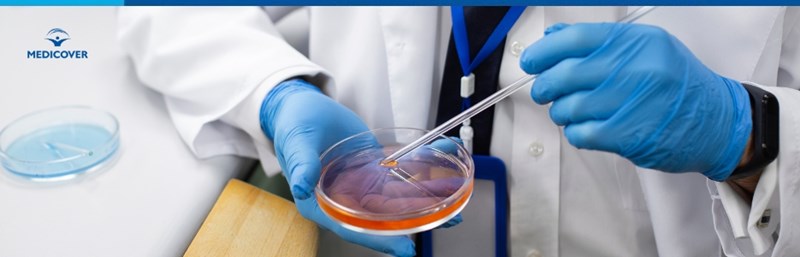

Transmiterea patogenului bacterian are loc prin intermediul ingestiei de alimente si apa contaminate, rezervorul natural al Salmonelei fiind reprezentat de tractul gastro-intestinal uman si animal. Alimentele contaminate in mod frecvent cu Salmonella sunt:
- Carnea cruda
- Laptele nepasteurizat
- Ouale sau produsele derivate din oua crude de tipul maionezelor.
Cuprins
- Infectie cu Salmonella simptome
- Simptome Salmonella la copii
- Forme severe de salmoneloza la copii
- Surse de contaminare cu Salmonella
- Diagnostic – teste si analiza Salmonella
- Tratament infectie cu Salmonella
- Regimul alimentar in infectia cu Salmonella
- Cum putem sa prevenim infectia cu Salmonella?
Sumar: - Salmonella afecteaza atat copiii, cat si adultii, cu riscuri mai mari pentru cei mici. |
Infectie cu Salmonella simptome
Tabloul clinic al salmonelozei este frecvent alcatuit din urmatoarele manifestari:
- Scaune apoase
- Crampe abdominale
- Senzatie de greata
- Varsaturi
- Febra
- Frisoane
- Cefalee
- Eliminarea de scaune cu striuri de sange.
Perioada de incubatie a Salmonelei de la momentul ingestiei alimentelor/apei contaminate si pana la aparitia manifestarilor specifice poate fi cuprinsa intre 6 ore si 6 zile, fapt care ingreuneaza realizarea anchetei epidemiologice in vederea identificarii sursei de contaminare bacteriana.
Manifestarile clinice ale salmonelozei se pot extinde pe o perioada de maxim 10 zile inregistrand in medie o saptamana de evolutie. Dereglarea tranzitului intestinal poate persista, insa mai multe luni dupa remiterea infectiei din cauza capacitatii bacteriei de alterare a florei digestive fiziologice. In anumite regiuni geografice reprezentate in special de tarile asiatice in curs de dezvoltare, exista tulpini de Salmonella care pot genera aparitia febrei enterice cu evolutie indelungata cunoscuta sub denumirea de febra tifoida.
Simptome Salmonella la copii
Infectia cu Salmonella la copii prezinta risc crescut de evolutie nefavorabila din cauza imaturitatii fiziologice a sistemului imunitar si a mecanismelor compensatorii insuficient dezvoltate la aceasta categorie de varsta. Salmoneloza la copil se manifesta in mod frecvent prin:
- Scaune diareice frecvente
- Crampe abdominale
- Senzatie de greata si varsaturi
- Deshidratare
- Iritabilitate
- Refuzul alimentatiei
- Stare generala alterata.
Raspunsul vascular generat de catre actiunea endotoxinelor specifice Salmonellei este mai accentuat in cazul copiilor si se manifesta prin cresterea permeabilitatii si diminuarea tonusului vascular.
Forme severe de salmoneloza la copii
Formele severe de salmoneloza pot determina pierderi importante de lichide prin intermediul varsaturilor si scaunelor diareice ale copilului, existand riscul de aparitie al dezechilibrelor hidro-electrolitice si al socului hipovolemic (insuficienta circulatorie acuta consecutiva diminuarii rapide a volumului sangvin circulator).
Socul septic reprezinta o alta complicatie a infectiei cu Salmonella care poate aparea la copii si se datoreaza unei insuficiente circulatorii acute de cauza septica (Salmonella disemineaza de la nivel intestinal prin intermediul circulatiei sangvine determinand septicemie).
Call Center
In prezenta unei evolutii severe sau prelungite a simptomelor digestive si/sau sistemice cauzate de salmoneloza este necesara prezentarea cat mai rapida la medic pentru efectuarea de analize in vederea diagnosticarii si initierii terapiei specifice antibacteriene si suportive. Parintii trebuie sa fie atentie la urmatoarele simptome:
- Febra inalta
- Deshidratare acuta - plans fara lacrimi, oligurie/anurie (lipsa ori productie foarte scazuta de urina, respectiv de materii fecale), ochi infundati in orbite, fontanela deprimata, pliu cutanat persistent, transpiratie cleioasa, somnolenta sau letargie
- Scaune cu sange sau mucus ale copilului.

Surse de contaminare cu Salmonella
Alimentele contaminate in mod frecvent cu salmonella sunt reprezentate de:
- Carnea de pasare crescuta in curte, carnea de porc si vita in cazul in care sunt consumate in stare cruda sau dupa preparare termica insuficienta (rare ori medium).
- Oua si derivate ale acestora – sosuri, maioneze, creme pentru prajituri pe baza de ou crud
- Lapte si produse din lapte nepasteurizate.
- Dulciuri sau prajituri care contin creme insuficient procesate termic (bain marie) preparate din oua sau lapte contaminat cu Salmonella.
Este important de retinut faptul ca alimentele pot fi contaminate atat inainte de preparare, cat si in timpul gatirii si al depozitarii, prin intermediul mainilor nespalate si al ustensilelor de bucatarie incorect igienizate.
Diagnostic – teste si analiza Salmonella
Diagnosticul de salmoneloza este stabilit de catre medicul infectionist pe baza anamnezei, examenului clinic si nu in ultimul rand al investigatiilor de laborator. In prezenta unei suspiciuni de infectie cu Salmonella, medicul curant recomanda efectuarea unei coproculturi pentru izolarea agentului etiologic si realizarea antibiogramei specifice in vederea initierii antibioterapiei.
In anumite situatii, diagnosticul poate fi stabilit pe baza metodelor rapide de detectie moleculara PCR care presupun identificarea materialului genetic bacterian prezent la nivelul scaunelor diareice emise de catre pacient.
Tratament infectie cu Salmonella
- Tratamentul suportiv in cazul infectiei cu Salmonella are ca scop restabilirea echilibrului hidroelectrolitic si compensarea pierderilor lichidiene de la nivelul tractului digestiv. Acesta se realizaza prin administrarea intravenoasa de electroliti sau solutii de rehidratare orala.
- Tratamentul simptomatic in cazul infectiei cu Salmonella are ca scop reducerea sindromului febril si al disconfortului algic determinat de acesta, al cefaleei si al crampelor abdominale. Tratamentul consta in administrarea de antitermice si antidiareice.
- Terapia etiologica are ca scop indepartarea agentului bacterian din organism si presupune administrarea de antibioterapice in conformitate cu sensibilitatea germenului la diverse clase de antibiotice. Tratamentul antibiotic trebuie administrat cu discernamant in conformitate cu indicatiile medicului curant, pentru a preveni selectarea de tulpini multi drug rezistente ESBL greu de tratat. Aceasta constituie o problema din ce in ce mai intalnita in practica medicala curenta.
Regimul alimentar in infectia cu Salmonella
Regimul alimentar al pacientilor cu salmoneloza, adulti si copi, prevede excluderea consumului de:
- Fructe crude
- Legume crude
- Oua
- Sucuri de fructe
- Bauturi carbogazose
- Alcool la adulti
- Alimente prajite
- Dulciuri
- Condimente
- Lapte si produse derivate ale acestuia
- Varza
- Fasole
- Carne procesata de tipul mezelurilor
- Carne tocata.
Refacerea tranzitului intestinal este favorizata prin consumul de:
- Paine prajita
- Covrigi
- Sticksuri
- Grisine
- Telemea cu continut scazut de grasimi
- Supa de orez si morcovi
- Banane
- Mar copt
- Carne slaba pregatita prin fierbere sau la gratar
- Apa plata
- Ceaiuri de menta.
Cum putem sa prevenim infectia cu Salmonella?
Prezenta Salmonellei in alimente nu modifica aspectul, mirosul sau gusrul acestora, astfel ca este deosebit de importanta respectarea regulilor de igiena in timpul manipularii si depozitarii hranei.
- Carnea trebuie gatita in mod corespunzator la temperaturi cat mai inalte
- Laptele si produsele derivate trebuie pasteurizate inainte de ingestie
- Apa provenita din surse nesigure trebuie fiarta si racita inainte de a fi consumata.
Practicile de manipulare a alimentelor trebuie sa includa in mod obligatoriu:
- Spalarea oualor cu apa calda si sapun inainte de utilizare pentru indepartarea excrementelor de pasare care pot contamina continutul in timpul manipularii.
- Spalarea legumelor si a fructelor, mai ales a celor care se consuma in stare cruda.
- Igienizarea corespunzatoare a suprafetelor de lucru din bucatarie (blaturi de lucru, tocatoare, masini de tocat carne), a veselei si a instrumentelor de gatit utilizate in timpul pregatirii hranei.
- Igienizarea corespunzatoare a mainilor inainte de pregatirea alimentelor si in timpul manipularii diferitelor produse alimentare. Dupa manipularea de carne cruda sau oua, mainile trebuie spalate inainte de a trece la alt produs alimentar.
- Diminuarea riscului de contaminare incrucisata cu Salmonella prin intermediul carnii crude, a sangelui animal sau excrementelor animale care pot intra in contact cu alimente gata pregatite pentru consum.
Animalele de companie exotice de tipul reptilelor, broastelor testoase, serpilor sau soparlelor trebuie tinute departe de bucatarie, varstnici, copii sau persoane cu sistem imunitar incompetent, din cauza riscului de transmitere al Salmonelei prin intermediul dejectiilor acestora. Igienizarea regulata a mainilor dupa utilizarea toaletei si inainte de masa previne cu succes atat infectiile gastro-intestinale cu Salmonella, cat si al celor determinate de alte tipuri de bacterii, virusuri si paraziti cu poarta de intrare digestiva.
Referinte:
- Salmonella, Centers for Disease Control and Prevention
- Salmonella: A Postmodern Pathogen, Robert V. Tauxe
- Salmonella in Domestic Animals, C. Wray, A. Wray
- Salmonella, the host and disease: a brief review, Bryan Coburn, Guntram A. Grassl, B. B.
Intrebari Frecvente (FAQ)
1. Cine este mai predispus la infectia cu Salmonella?
Infectia cu Salmonella poate afecta atat copiii, cat si adultii, dar copiii au un risc crescut de evolutie nefavorabila din cauza imaturitatii sistemului lor imunitar.
2. Cum imi dau seama daca eu sau copilul meu avem salmoneloza?
Simptomele comune ale salmonelozei includ scaune diareice frecvente, crampe abdominale, greata, varsaturi, febra si stare generala alterata, iar la copii este important sa se monitorizeze deshidratarea.
3. Ce trebuie sa fac daca simptomele nu dispar?
Daca simptomele digestive sau sistemice se agraveaza sau persista, este necesar sa se consulte un medic pentru analize si posibilitatea initierii unei terapii specifice antibacteriene.
4. Care sunt metodele prin care se poate preveni infectia cu Salmonella?
Preventia infectiei cu Salmonella se realizeaza prin respectarea igienei alimentare, astfel incat carnea sa fie gatita la temperaturi adecvate, ouale si laptele sa fie pasteurizate, iar alimentele sa fie manipulate corect.